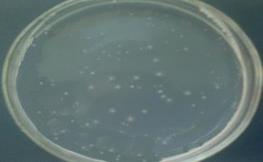

Антимутагенные и мутагенные свойства лекарственных растений
СОДЕРЖАНИЕ
СПИСОК
СОКРАЩЕНИЙ
ВВЕДЕНИЕ
ГЛАВА
1. ОБЗОР ЛИТЕРАТУРЫ
1.1 Антимутагенез. Основные классы
антимутагенов. Десмутагены
.1.1 Антимутагены растительного происхождения
.2 Химический состав и свойства Chelidonium
majus L
1.3
Функции алкалоидов в растениях
.4
Химический состав и свойства Cichorium intybus L
.5
Химический состав и свойства Тussilago farfara L
ГЛАВА
2. ЭКСПЕРЕМЕНТАЛЬНАЯ ЧАСТЬ
.1
Материалы и методы исследований
.1.1
Растительный материал
.1.2
Метод выделения алкалоидов чистотела большого
.1.3
Бактериальные тест-системы для определения токсических эффектов соединений
природного происхождения
.1.4
Бактериальные тест-системы для определения мутагенных эффектов соединений
природного происхождения
.1.5
Бактериальные тест-системы для определения антимутагенных эффектов соединений
природного происхождения
.1.6
Статистическая обработка результатов
.2
Результаты исследований и их обсуждение
.2.1
Определение токсического действия препаратов лекарственных растений Chelidonium
majus L., Тussilago farfara L.,
Cichorium intybus L. на выживаемость штамма Salmonella
typhimurium
TA 100
.2.2
Мутагенный эффект лекарственных растений Chelidonium majus L., Тussilago
farfara L., Cichorium
intybus L. на выживаемость штамма Salmonella
typhimurium
TA 100
.2.3
Антимутагенный эффект лекарственных растений Chelidonium majus L., Тussilago
farfara L., Cichorium
intybus L. на выживаемость штамма Salmonella
typhimurium
TA 100
ВЫВОДЫ
СПИСОК
ИСПОЛЬЗОВАННЫХ ИСТОЧНИКОВ
СПИСОК СОКРАЩЕНИЙ
Ал
- алкалоиды
БАВ
- биологически активные вещества
ВЭЧ
- водный экстракт чистотела большого (Chelidonium
majus L.)
ВЭМ
- водный экстракт мать-и-мачехи обыкновенной (Тussilago
farfara L.)
ВЭЦ
- водный экстракт цикория обыкновенного (Cichorium
intybus L.)
ГПС
- глюкозо-пептонная среда
ГПА
- глюкозо-пептонный агар
ДМСО
- диметилсульфоксид
СЧ
- сок чистотела
ВВЕДЕНИЕ
Одной из важнейших задач современной медицины
является профилактика и коррекция последствий загрязнения окружающей среды для
человека. Эта проблема, помимо возрастания естественного фона радиации,
находится в тесной связи с постоянным поступлением в окружающую среду отходов
промышленных производств и применяемых в сельском хозяйстве химикатов.
Указанная задача относится к числу важных также в связи с расширением арсенала
химических соединений в промышленности, быту, медицине и научных исследованиях
[Ефимов, 2001].
Все упомянутые и другие факторы риска влияют на
генетический аппарат, который отвечает за точность воспроизводства свойств и
признаков в поколениях, а также за выполнение роли регулятора всех протекающих
в организме процессов. Как следствие действия мутагенов в настоящее время
отмечается эскалация мутаций, врожденных уродств, злокачественных
новообразований. Поскольку исключить контакт человека с мутагенными факторами практически
невозможно, важное значение приобретает поиск природных антимутагенов,
способных предотвратить генотоксичное действие внешнесредовых факторов
[Бариляк, 1994].
Перспективность использования растительных
препаратов в медицине обусловлена также возможной минимизацией их токсических
эффектов в млекопитающих, что объясняется сходным химическим составом
биологически активных веществ живых организмов, а также определенным сродством
метаболизма растительной и животной клетки [Коломиец, Ефимов, 2005].
С данной точки зрения интерес представляет
чистотел большой(Chelidonium majus L.). Чистотел большой в последние
десятилетия привлекает большое внимание исследователей. Из него получены
десятки галеновых, неогаленовых и полусинтетических препаратов. В большинстве
изданий, по лекарственным растениям, по чистотелу приводятся данные по
качественному составу алкалоидов, откуда можно заключить, что количество
алкалоидов в чистотеле, включая минорные, доходит до 28 [Волощук, Потопальский,
2010]. Ранее было показано выраженное антигенотоксическая активность соков
Chelidonium majus L., а также мать-и-мачехи обыкновенной Tussilago farfara L.
[Карамова с соавт., 2010]. По-видимому, данные эффекты были обусловлены
комплексом физиологически активных веществ, в первую очередь алкалоидов. В
отличие от этих объектов исследовании, сведения по биоантимутагенной активности
цикория обыкновенного (Cichorium intybus L.), несмотря на широкое его
применение в фитотерапии [Пащенко с соавт., 2007], отсутствуют.
В связи с этим целью настоящей работы явилось
сопоставление антимутагенных свойств водных экстрактов лекарственных растений,
цикория обыкновенного, мать-и-мачехи обыкновенной, чистотела большого и его
алкалоидов.
В соответствии с поставленной
целью решались следующие задачи:
1. Определить токсические эффекты водных
экстрактов и алкалоидов лекарственных растений чистотела большого (Chelidonium
majus L.), цикория обыкновенного (Cichorium intybus L.) и мать-и-мачехи
обыкновенной (Tussilago farfara L.).
. Охарактеризовать возможность модуляции
уровня индуцированных мутаций лекарственных растений тесте Эймса.
. Оценка антимутагенной активности водных
экстрактов и алкалоидов лекарственных растений чистотела большого, цикория
обыкновенного и мать-и-мачехи обыкновенной тесте Эймса.
ГЛАВА 1. ОБЗОР ЛИТЕРАТУРЫ
.1 Антимутагенез. Основные
классы антимутагенов
антимутаген алкалоид лекарственный растение
Антимутагенез - биологическое
явление подавления мутационного процесса, выражающееся в снижении спонтанного и
индуцированного мутирования под действием природных и синтетических соединений
[Алекперов, 2009].
В 1952-1957 гг. А. Новик и Л.
Сцилард в опытах с кишечной палочкой впервые показали, что введение в среду
аденозина, гуанозина и ионозина (пуриновые рибонуклеозидами) снижает частоту
мутаций [Порошенко и Абилев, 1988]. В дальнейшем соединения, у которых
выявились подобные свойства, стали обозначать термином «антимутагены», по
аналогии с мутагенами, которые повышают уровень мутирования [Алекперов, 2009].
Синонимами являются термины «протектор» и «модификатор». Само явление снижения
мутаций было названо «антимутагенезом». С этих пор открыто много новых веществ,
снижающих частоту индуцированных мутаций, и к настоящему времени их
насчитывается около сотен природных и синтетических соединений: витаминов,
аминокислот, естественных метаболитов, пищевых добавок, лекарств и некоторых
других органической и неорганической природы. Большинство антимутагенов
эффективны не только против процессов индуцированного мутагенеза, но и против
канцерогенеза. Антимутагены могут служить инструментом для познания механизмов
мутагенеза и модификации этого процесса, как в сторону его усиления, так и в
сторону ингибирования.
Одна из первых попыток
систематизировать антимутагены была предпринята У.К. Алекперовым, который выделил
6 групп соединений:
·
вещества,
влияющие на синтез нуклеиновых кислот и белков;
·
фармакологические
средства;
·
аминокислоты
и другие метаболиты;
·
комплексные
природные соединения;
·
ингибиторы
свободно радикальных процессов;
•витамины и ферменты.
Согласно классификации T. Kada
[Kada, 2006], антимутагены подразделяются на 4 группы:
·
вещества,
инактивирующие мутагены, - десмутагены;
·
вещества,
влияющие на метаболизм и транспорт мутагенов;
·
вещества,
уменьшающие ошибки репарации и репликации;
·
антимутагены
с неизвестным механизмом действия.
На основе известных
представлений о токсикогенетике мутагенов Г.Г. Порошенко и С.К. Абилев
[Порошенко и Абилев, 1988] предложили сходную классификацию
·
десмутагены;
·
метаболические
антимутагены, влияющие на метаболизммутагенов;
·
мембранные
антимутагены, влияющие на проницаемостьмембран;
·
антимутагены,
связывающие активные радикалы;
·
репарационные
антимутагены.
Однако в ней не нашли отражения
представления о возможном антимутагенном действии за счёт стабилизации
структуры [Семёнов, 1995], индукции формирования эндогенных антимутагенов
(интерферон, убихинон и др.) [Гончарова, 1993], о роли аденилатциклазного
комплекса в формировании эффектов антимутагенов. Последний механизм обоснован
совсем недавно и предполагает, что антимутагенное действие ряда соединений
может быть реализовано через систему вторичных мессенжеров. Это позволяет
объяснить эффекты низких концентраций и доз антимутагенов их триггерными
свойствами [Семёнов с соавт., 1994]. Весьма вероятно, что при дальнейшем
развитии исследований антимутагенеза будут выявлены новые механизмы и
углубляться представления об уже известных механизмах действия антимутагенов.
При изучении антимутагенных свойств одного и того же вещества авторы применяют
различные тест-объекты (от бактерий до клеток человека in vitro и in vivo),
индукторы мутагенеза, дозы и пути введения веществ и сроки их экспозиции в
организме. Все известные антимутагены можно разделить на два основных класса:
десмутагены, к которым относятся соединения, снижающие активность мутагенов до
начала их взаимодействия с различными системами организма, и биоантимутагены -
вещества, изменяющие реакцию организма на мутагены [Алекперов, 2009].
Десмутагены В настоящее время
выявлен целый ряд соединений, способных инактивировать мутагенный агент или
предупреждать его образование в химических реакциях in vivo [Kada, 2007].
Антимутагенные вещества десмутагенного действия содержатся в ряде растений
[Sato etal., 2006]. Гуминовая кислота способна адсорбировать бензапирен,
3-аминоантрацен, и таким образом предупреждать их повреждающее действие на
генетические структуры Salmonella typhimurium [Sato etal., 2006].
Парааминобензойная кислота, взаимодействуя с некоторыми мутагенами, подавляет
их активность [Gichner etal., 2008]. Глутатион в желудочно-кишечном тракте
инактивирует мутагенные электрофилы и тем самым препятствовать их мутагенному
действию на организм [De Flora, Ramel, 2004]. Аскорбиновая кислота, витамин Е,
ряд природных и синтетических фенолов, реагируя с амидами, аминами и нитратами,
препятствуют образованию нитрозомутагенов [Ramel etal., 2007].
.1.1 Антимутагены растительного
происхождения
В последнее время наблюдается
возросший интерес к лекарственным препаратам растительного происхождения.
Модификаторы биологических реакций растительного происхождения выгодно
отличаются от остальных: сведения о токсичности, как цельных препаратов, так и
выделенных из растений химически чистых веществ, в доступной литературе
практически не встречаются. Одним из несомненных преимуществ фитотерапии
является и то, что растения хорошо совмещаются как между собой, так и с
обычными синтетическими препаратами. В комплексе они часто усиливают действие
друг друга, у них гораздо более широкий спектр действия по сравнению с
химиопрепаратами. В США ежегодная прибыль от продажи лекарственных трав и
соответствующих препаратов составляет 2 биллиона долларов [Сraig, 2010].
Растения одними из первых были
изучены в качестве источника антимутагенных соединений. Большинство данных об
антимутагенных эффектах растительных экстрактов получено японскими учеными
[Kada, 2006].
Первоначально было показано,
что мутагены окружающей среды могут быть инактивированы некоторыми овощными
экстрактами. В частности, было показано, что экстракты капусты, редиса, цветной
капусты содержат антимутагенные агенты, инактивирующие продукты метаболизма
нитрата натрия. Одновременно было установлено, что соки, приготовленные из
капусты, зеленого перца, имбиря, брокколи, цветной капусты обладают
антимутагенным действием против продуктов пиролиза триптофана, образующихся в
результате сгорания табака, приготовления мяса и рыбы [Kada, 2006]. При
изучении антимутагенного действия экстрактов из 59 видов овощей и фруктов в
условиях индукции мутаций продуктами пиролиза цитрулина, лизина, орнитина,
аргинина Кada с соавт. была показана высокая десмутагенная активность для
экстрактов из 10 продуктов: капусты, зеленого перца, брокколи, баклажан, яблок,
лопуха, лука, имбиря, ананаса, листа мяты [Kada, 2006].
Антимутагенность свойственна
экстрактам некоторых злаковых растений. Было показано, что экстракты пшеницы,
кукурузы, проростков гороха подавляют действие непрямых мутагенов, что,
очевидно, связано с модификацией процесса метаболической активации промутагенов
[Алекперов, 2009].
В работе Кada с соавт. (2006) исследованы
биоантимутагенные свойства экстрактов 303 различных растений по ингибированию
индуцированных УФ-светом мутаций в E. coliB/r WP2 (trp). Эффект был обнаружен
только для 16 растений, что, очевидно, обусловлено присутствием в них
определенных соединений, обладающих антимутагенной активностью.
Следующий этап в исследовании антимутагенного
эффекта растений связан с выделением и идентификацией различных компонентов,
ответственных за данный эффект.
Растения содержат алкалоиды, ферменты,
растительные гормоны, фитонциды, антибиотики и целый ряд микроэлементов, то
есть все те вещества, которые играют огромную роль в обмене веществ и, в
частности, роль катализаторов. Антимутагены, выделенные из растений: хлорофиллы
а и б, хлорофиллин, таниновая, галловая, эллаговая, хлорагеновая, парагидроксибензйная
и другие кислоты, многие витамины (аскорбиновая кислота, токоферол, витамины А,
К, парааминобензойная кислота и др.) [Гончарова, 1993].
Экстракты многих растений содержат большое
количество фенольных соединений - флавоноиды, дубильные вещества, антра - и
нафтохиноны, ксантоны, фенолгликозиды и др. [Wojdylo etal., 2007].
Антимутагенные свойства этой группы соединений впервые показали Рилей и Гофф в
1960 г. [Алекперов, 2009]. Общим свойством этих веществ является их
антиоксидантная активность, способность подавлять свободные радикалы, уменьшать
их концентрацию в клеточных мембранах. Благодаря антиоксидантной и
мембранопротекторной функции, они влияют на иммунологические свойства, защищают
молекулы ДНК от повреждающего действия интермедиантов и переокисления. Кроме
того, флавоноиды, оксикумарины при окислении переходят в хиноидную форму,
благодаря чему взаимодействуют с ДНК, снижают антиокислительную активность
липидов, т.е. снижают их жизнеспособность. Растения, содержащие фенолгликозиды
и флавоноиды, обладают мочегонным и гепатопротекторным действием, что
способствует обезвреживанию и удалению токсинов и шлаков. Установлено, что
антиоксидантное действие демонстрируют многие растения, используемые в качестве
специй - розмарин, орегано, шалфей, кориандр, гвоздика, корица. При
исследовании экстрактов 32 видов трав Войдело с соавт. [Wojdylo etal., 2007].
Изучении антиоксидантной активности фенольных растений, содержащихся в было
показано, что высокая антиоксидантная активность данных растений обусловлена содержанием
в них фенольных кислот и флавоноидов.
Антимутагенным действием обладают терпены,
содержащиеся в эфирных маслах различных растений: Lavandula angustifolia L.,
Coriandrum sativum L., Laurusno bilis L. и др. Терпены и их производные могут
быть использованы для профилактики и лечения различных заболеваний, включая
рак. Так, некоторые терпены ингибируют развитие карцином печени, кожи, легких и
т.д. b
- Кариофиллин, компонент многих эфирных масел (например, из гвоздики, черного
перца) показал сильный антимутагенный эффект, индуцируя фермент
детоксикацииглутатион -S-трансферазу [DiSottoetal., 2008].
Рядом исследований установлено, что
тритерпеновые сапонины интенсивно угнетают метаболизм канцерогенов. Сапонины
календулы оказались сильным ингибитором мутагенеза в тесте Эймса [Шлянкевич с
соавт., 1992]. Антимутагенная активность обнаружена и у катехинов, выделенных
из чайных растений [Гончарова, 1993].
Хлорофилл и его водорастворимое производное
хлорофиллин показывают значительную биологическую активность, сопряженную с
антиканцерогенным действием, включающим антиоксидантную, антимутагенную
активности, способность блокировать активацию промутагенов ферментами микросом,
[Шлянкевич с соавт., 1992; Ferruziand Blakeslee, 2007].
Витамин А и каротиноиды, аскорбиновая кислота
являются важной группой биологически активных веществ растений, их
антимутагенная активность показана при исследовании различных видов растений.
Антимутагенные свойства витамина Е (токоферола),
витамина С (аскорбиновая кислота), витамина В (фолиевая кислота) впервые были
установлены еще в 70-х годах XX века. Эксперименты на растительных объектах и
культуре, клеток лимфоцитов человека показали, что эти витамины эффективно
уменьшают мутагенное действие ионизирующих излучений и химических канцерогенов.
Были исследованы две популяции природных злаков - эгилопсов, произрастающих в
естественных условиях на разных уровнях вертикальной зональности. Анализы
показали, что чем больше токоферолов содержалось в клетках растений, тем
устойчивее был их генетический аппарат к действию мутагенных факторов
(радиация).
На сегодняшний день экспериментальными и
клиническими наблюдениями убедительно доказана перспективность использования
растений, обладающих антимутагенной активностью, в комбинированной терапии онкологических
заболеваний. Особый интерес вызывают препараты, повышающие противоопухолевую
резистентность, препятствующие развитию метастазов и рецидивов опухолей,
снижающие токсические проявления химиотерапии. Кроме классической фитотерапии,
где используются отдельные растения, на основе травяных сборов сейчас в мире
выпускается около 1200 пищевых добавок (БАД), которые широко применяются в
комплексном лечении и для профилактики заболеваний. Сегодня, несмотря на
большие успехи в создании химических лекарств, интерес к природным, целительным
веществам и создаваемых на их основе БАД снова возрос. Обычные лекарственные
растения по сравнению с химическими препаратами и ядовитыми растениями
действуют на организм мягче, они, как правило, не вызывают аллергии - специфической
реакции протеста.
1.2 Химический состав и свойства чистотела
большого (Chelidonium majus L.)
Трава содержит более 20 алкалоидов (хелидонин
рисунок 1, хелеритрин, сангвинарин, протопин и др.), эфирные масла, витамин С
(аскорбиновая кислота) (от 170 до 1000 мг %), витамин А (каротин) (до 14,9 мг
%), флавоноиды, сапонины и органические кислоты (лимонную, яблочную, янтарную и
хелидоновую).

Рисунок 1. Общее строение хелидонина
Алкалоиды - это азотсодержащие органические
вещества, которые характеризуются высокой физиологической активностью. В малых
дозах алкалоиды являются лекарствами, в больших - ядами [Андреева, 2005].
Присутствие алкалоидов в траве составляет
0,27-2,25%, а в корнях - от 1,90 до 4,1%. Состав алкалоидов является достаточно
сложным и по структуре может быть соотнесен к изохинолиновым производным и их
различным видам. Следует заметить, что в чистотеле алкалоиды присутствуют как в
связанном состоянии с хелидоновой кислотой (по структуре сходна с меконовой),
так и свободном. Данное растение характеризуется наличием алкалоидов следующих
подгрупп:
подгруппа протопина, включает протопин,
аллокриптопин;
подгруппа протоберберина, включает берберин,
коптизин, стилопин;
подгруппа бензофенонтридина, включает хелидонин,
хелеритрин, хелирубин, сангвиритрин, азотсодержащие соединения - тирамин,
холин, гистамин [Барабанов, 2006].
Алкалоиды чистотела обладают разнообразными
свойствами: хел хелидонин оказывает действие, подобное морфину (болеутоляющий и
успокаивающий эффект), гомохелидонин действует как судорожный яд, сангвинарин
возбуждает секрецию слюнных желез, усиливает перистальтику кишечника, обладает
наркотическим действием, протопин тонизирует гладкую мускулатуру матки и
снижает порог возбудимости вегетативной нервной системы (нервная система,
иннервирующая внутренние органы).
О метоксихелидонине следует, однако сказать, что
это не индивидуальный алкалоид, а смесь, как было доказано в 1994 г, трех
алкалоидов - (+)-хеламина, (+)-гомохелидонина и (+)-хеламидина в соотношении
67:28:5%, то есть, к предыдущим следует причислить еще два алкалоида. В
монографии [Потопальский,1992] кроме этих алкалоидов дополнительно значатся:
коризамин, тетрагидрокоризамин, хелидимерин, сангвидимерин, хелидамин, а о
спартеине уточняется, что он присутствует в d-,
l- и dl-формах.
Согласно требованиям Фармакопеи Украины для
аптечной сети в настоящее время используют заготовки травы чистотела, собранной
в период цветения. Однако давно известно, что корни растения и его надземная
часть отличаются между собой как по составу, так и по соотношению входящих в
них алкалоидов. Кроме того, это соотношение колеблется также и в зависимости от
условий вегетации, времени сбора сырья и места произрастания чистотела.
В работах чехословацких ученых Ю. Славика и Л.
Славиковой с сотрудниками, посвятивших практически все свои труды изучению
алкалоидов разных видов растений, достаточно внимания уделено выделению
алкалоидов из чистотела большого. Наиболее полно ими изучен алкалоидный состав
корней растения [Slavik
с соавт., 2005], когда ими было выделено в чистом виде более 480 г алкалоидов
(из 68 кг аптечного сырья), что составило 0.71%-ный выход идентифицированных
алкалоидов (истинное содержание алкалоидов, надо полагать, заведомо выше).
Среди выделенных алкалоидов свыше 63% суммарного состава приходилось на
хелидонин, затем шел протопин - порядка 20%, аллокриптопин ~10.5% и
гомохелидонин ~ 2%. Чуть меньше 2% пришлось на долю вместе взятых сангвинарина,
хелеритрина, хелирубина, хелилютина. Коризамин, берберин и коптизин вместе
составили около 1%; стилопин, хеламин и хеламидин ~ 0.1, 0.2 и 0.3%,
соответственно.
В алкалоидном комплексе надземной части растения
(точнее - листовых пластинках и стеблях) согласно работе [Булатов с соавт.,
2006] количественно преобладают третичные бензофенантридины - гомохелидонин и
хелидонин. За ними следуют протопины (сам протопин, a
и b-аллокриптопины),
четвертичные протоберберины - берберин и коптизин, и наконец, четвертичные
бензофенантридины - сангвинарин и хелеритрин. Доминирующими алкалоидами в
листьях в начале вегетации являются гомохелидонин и протопин, тогда как
хелидонин присутствует в очень небольшом кoличестве.
Зато он, наряду с гомохелидонином, преобладает в стеблях. По мере роста
растения бензофенантридинов становится все больше в стеблях (почти в 2 раза), а
протоберберинов - в листьях (в 3-4 раза).
Относительно процентного содержания алкалоидов в
надземной части растения следует отметить, что оно наибольшее сразу после
таяния снега (~1,9% -2%), когда биомассы еще мало, а набор алкалоидов невелик.
В период цветения, когда накопление биомассы и разнообразие алкалоидного
состава достигают наибольших значений, процентное содержание алкалоидов в
надземной части растения снижается (~0.82%) и становится вполне сопоставимым с
его содержанием в корнях. Основным в смеси алкалоидов надземной части являются
гомохелидонин и хелидонин. Берберин составляет (в отличие от содержания в
корнях) свыше 11 % от суммы алкалоидов и сосредоточен преимущественно в
листьях. Сангвинарин и хелеритринобнаружены в основном в стеблях и притом в
очень небольших количествах. Однако их содержание к осени резко возрастает (до
9 %)
1.3 Функции алкалоидов в растениях
Функции алкалоидов в растениях не вполне
понятны. Возможно, алкалоиды - это побочные продукты обмена веществ
(метаболизма) в растениях, или они служат резервом для синтеза белков,
химической защитой от животных и насекомых, регуляторами физиологических
процессов (роста, обмена веществ и размножения) или конечными продуктами
детоксикации, обезвреживающей вещества, накопление которых могло бы повредить
растению. Каждое из этих объяснений может быть справедливым в конкретных
случаях, однако 85-90% растений вовсе не содержат алкалоидов [Племенков, 2001].
Фармакологическая активность алкалоидов
изменяется в широких пределах в зависимости от структуры. Среди них имеются
обезболивающие средства и наркотики (морфин, кодеин); мощные стимуляторы центральной
нервной системы (стрихнин, бруцин), мидриатические (т.е. расширяющие зрачок)
средства (атропин, гиосциамин) и миотические (т.е. суживающие зрачок) средства
(физостигмин, пилокарпин). Некоторые алкалоиды обнаруживают адренергическую
активность, возбуждают симпатическую нервную систему, стимулируют сердечную
деятельность и повышают кровяное давление (эфедрин, эпинефрин). Другие -
снижают кровяное давление (резерпин, протовератрин А). Благодаря своей
физиологической активности многие алкалоиды, будучи сильными ядами, находят
применение в медицине [Веселовская, 2000].
Биологическая роль алкалоидов окончательно не
выяснена. С. Ю. Юнусов (1948) считает, что алкалоиды при дыхании растений
окисляются в пероксид, который переходит в оксид алкалоида, а освобождающийся
при этом активированный кислород используется растением для дальнейшего
фотосинтеза. Алкалоиды подземных частей, по-видимому, регулируют рост и обмен
веществ [Aniszewski, 2007].
1.4 Химический состав и свойства цикория
обыкновенного (Cichorium intybus L.)
В корнях цикория обнаружено до 40-60%
полисахарида инулина, белковое вещество, дубильные вещества, глюкозы, левулезы,
хлорогеновая, изохлорогеновая и аскорбиновая кислоты, витамины группы В, холин,
жиры, гликозиды (интибин, цикорин, лактуцин), пектин. В надземной части
растения концентрация инулина колеблется от 40 до 50%. В корнях и листьях
обнаружен холин, следы витамина К [Государственная фармокопея, 1990].
При поджаривании корней цикория из углеводов и
белков корня образуется цикориоль, в составе которого обнаружены уксусная,
валериановая кислоты, акролеин, фурфурол, фурфуровый спирт. В цветках
обнаружены кумариновые гликозиды (цихорин, эскулетин-гликозид и эскулин). В
листьях - инулин, аскорбиновая и цикориевая кислоты[Fattorusso, 2008]. Растение
богато млечным соком, в котором найдены горькие вещества (лактуцин,
лактукопикрин, тритерпеновый спирт тараксастерол). Семена содержат инулин,
жидкое масло и пирокатехиновый альдегид. Содержание витаминов и минеральных
веществ (в мг %): каротина - 1,3, С - 10,2, B1 - 0,05, В3 - 0,003, РР - 0,24,
натрия - 4,4, калия - 1,92, марганца - 12, кальция - 26, железа - 0,7, фосфора
- 25 [Племенков, 2001].
Отвар дикорастущего цикория обладает
противомикробным, противовоспалительным и вяжущим действием. Согласно
экспериментальным данным, настой соцветий дикорастущего цикория при
парентеральном введении оказывает успокаивающее действие на центральную нервную
систему и усиливает деятельность сердца, увеличивая амплитуду и замедляя ритм
сердечных сокращений. Кроме того, цикорий улучшает аппетит, усиливает
пищеварение, повышает выделение мочи и желчи, прекращает поносы. Отвар семян
обладает обезболивающим, жаропонижающим и потогонным действием [Fattorusso,
2008].
1.5 Химический состав и свойства мать-и-мачехи
обыкновенной (Tussilago farfara L.)
В листьях и цветках мать-и-мачехи содержатся:
слизь (7-8%), горькие гликозиды (2,6%), сапонины, каротиноиды, инулин, яблочная
и винная кислоты, аскорбиновая кислота, дубильные вещества [Веселовская, 2000].
В цветках мать-и-мачехи обнаружены стероидные
соединения фитостерин, стигмастерин, фарадиол, флавоноиды рутин (0,36%),
гиперозид (0,28%) и др [Племенков, 2001].
Противовоспалительное и мягчительное действие
настоев и отваров листьев мать-и-мачехи обусловлено слизями. Растекаясь по
слизистым оболочкам верхних дыхательных путей, слизи образуют защитную пленку,
предохраняющую эпителий от раздражающего влияния холода, ингредиентов пищи,
бактериальных токсинов, вирусов и др. Под защитной пленкой слизи снижается
активность воспалительных процессов, регенерирует поврежденный эпителий,
нормализуется его функция и движение ресничек [Веселовская, 2000].
Сапонины растения и органические кислоты
разжижают патологические секреты дыхательных путей, образующиеся в результате
воспаления, жизнедеятельности микроорганизмов и вирусов, способствуют более
быстрой эвакуации их, очищению дыхательных путей и восстановлению газообмена.
Противовоспалительное действие усиливают каротиноиды, дубильные вещества. Сумма
полисахаридов мать-и-мачехи на экспериментальных моделях воспаления дает
отчетливый противовоспалительный эффект, наиболее вероятно они обладают также
иммуностимулирующим действием. По противовоспалительной активности полисахариды
мать-и-мачехи не уступают индометацину, хотя фармакодинамика их различна
[Spiller, Caffeine, 1997].
Настои и отвар листьев обладают отхаркивающим,
мягчительным, противомикробным, потогонным, ранозаживляющим, желчегонным,
спазмолитическим действием и являются специфическим средством в комплексном
лечении при заболеваниях дыхательных путей (бронхиты, бронхиальная астма,
абсцесс легких, пневмония, гангрена легких).
Кроме того, мать-и-мачеху применяют в виде
водных извлечений при гастритах, язвенной болезни желудка и двенадцатиперстной
кишки, заболеваниях печени [Aniszewski, 2007].
ГЛАВА 2. ЭКСПЕРИМЕНТАЛЬНАЯ
ЧАСТЬ
.1 Материалы и методы
.1.1 Растительный материал
В работе использованы алкалоиды, водный экстракт
лекарственного растения чистотела большого (Ch. majus L.), водный экстракт
цикория обыкновенного (C. intybus L.), водный экстракт мать-и-мачехи
обыкновенной (T. farfaraL.).
Образцы водного экстракта из чистотела большого,
цикория обыкновенного, мать-и-мачехи обыкновенной были получены следующим
способом: измельченную сухую траву чистотела большого (2,5г) заливали кипящей
дистиллированной водой (50 мл/л) и кипятили в течение 15 мин. Полученный
экстракт фильтровали через 4-6 слоев марли, далее пропускали через мембранный
фильтр Synpor с диаметром пор 0,2 мкм. Стерильный экстракт разливали в пробирки
Эппендорф и хранили при температуре -20°C.
Перед исследованием соки растений разводили
стерильной дистиллированной водой до концентрации l:10, 1:100, 1:1000.
.1.2 Метод выделения алкалоидов чистотела
большого
Алкалоиды чистотела большого выделяли в
лаборатории алкалоидов Ташкентского института химии растительных веществ им.
академика С.Ю. Юнусова на основании методов, описанных А.П. Ореховым (1955).
Образцы алкалоидов из чистотела большого (Ch.
majus L.) были получены следующим способом: чистотел (235 г) измельчили в
ступке. К полученной массе добавили 5% соляную кислоту, после 1-часового
выдерживания заливали 1,5л аммиака на 2 ч. После этого добавляли хлороформ
таким образом, чтобы добиться полной экстракции веществ из сырья. Экстракцию
растения чистотела помещали в аппарат Сокслета, который в нашем случае
использовался как циркуляционный аппарат. Он убыстряет экстрагирование,
выполняя ее в один этап. На выходе получили экстракт, в который добавили 5 %
серную кислоту (H2SO4). В паровой перегонке кислоту смывали бензином для того,
чтобы очистить от масел. На выходе получили кислоту без масленых примесей.
После добавляется концентрированный аммиак, что бы получить щелочь. К щелочи
добавили хлороформ и получили хлор - экстракт. Общий вес суммы алкалоидов был
равен 1,3 г, что составляет 0,55 % от сухого веса лекарственного сырья.
Хроматограмма проводилась на пластинах Silufol
UV-254 в системе растворителей ТМА (толуол/ метанол/ 25% аммиак - 4:1:0.04)
[Волощук, 2010].
.1.3 Бактериальные тест - системы для
определения токсических эффектов соединений природного происхождения
В работе использовали штамм Salmonella
typhimurium:
ТА 100 (his G46, rfa, uvr-, pKm 101,
bio-), полученный из коллекции микроорганизмов каф.генетики МГУ (г.
Москва).
Проведение эксперимента:
. За 12-15ч. до проведения эксперимента
делают пересев культуры тестерного штамма с косяка в 5мл LB-бульона для
получения "ночной" культуры.
. 2% LB-агар разливают в чашки Петри.
. Делают разведения "ночной"
культуры в изотоничсеком 0,9% растворе NaCl.
. Растопленный 0.6% LB-агар разливали
стерильно по 3мл в пробирки и ставили в водяную баню при 45°С.
. В пробирки с 3мл полужидкого 0.6%
LB-агар вносили 0.1мл бактериальной суспензии нужного разведения и 0.1мл
вещества в исследуемой концентрации. Раствор перемешивали и наслаивали на
нижний 2% питательный агар в чашки Петри. В негативный контроль вместо вещества
добавляли 0.1мл растворителя. После 24ч. инкубации при 37°С
подсчитывают число колоний в опыте и контроле и вычисляют "процент
выживания" или степень токсичности вещества:
число
колоний в опыте
Процент выживания =
---------------------------------х 100%
число колоний
в контроле
Опыт проводят в 2 - 3-х повторностях. Если
процент выживания штамма составляет менее 3%, исследовать данную концентрацию в
опытах на мутагенность не следует.
Необходимые среды:
-LB-бульон: Пептон - 10 г, Дрожжевой экстракт -
5 г, NaCl- 5 г.
2-2% LB-агар Пептон - 10 г, Дрожжевой экстракт -
5 г, NaCl- 5 г, агар-8 г.
.1.4 Бактериальные тест - системы для
определения мутагенных эффектов соединений природного происхождения
Сущность теста заключается в том, что тестерные
штаммы бактерий Salmonella typhimurium культивируют на специальной среде, на
которой могут расти лишь мутанты этих штаммов, у которых произошла мутация от
ауксотрофности по гистидину к прототрофности. Без внешних воздействий такие
мутации происходят с низкой частотой. Если в среду культивирования ввести
химический мутаген, то частота мутаций значительно увеличивается, что
регистрируется по числу колоний микроорганизмов, выросших на данной селективной
среде. Подготовка культуры и исследуемых препаратов:
Культуру с косяка переносили петлей в 5 мл ГПС и
инкубировали при 37оС. При выращивании штаммов, несущих плазмиду рКm
101, в ГПС вносили ампициллин в концентрации 50мкг/мл.
В день постановки эксперимента 5мл
"ночной" культуры переносили в 20мл свежего LB-бульон и инкубировали
с принудительной аэрацией при 37оС в течение 2 - 2.5ч. Затем
культуру переносили в стерильные центрифужные пробирки и центрифугировали 20
мин при 5000 об/мин. на центрифуге (MPW-310, Польша). Осадок ресуспендировали в
0,02М фосфатном буфере или растворе солевого концентрата, разведенном 1:4.
Растворы исследуемых препаратов готовили в стерильной дистиллированной воде или
диметилсульфоксиде (ДМСО). Растворы препаратов готовили с таким расчетом, чтобы
при внесении в смесь 0,1 мл раствора доза препарата на чашку соответствовала бы
исследуемой.
Проведение эксперимента:
. В стерильные чашки Петри разливали
нижний агар.
. В пробирки разливали 0,6% верхний агар
по 3 мл с микродобавками биотина и гистидина и ставят на водяную баню при
температуре 45оС.
. В верхний агар вносили 0,1мл
бактериальной суспензии, 0,1 мл исследуемого соединения.
Предложена следующая система оценки соединений
на мутагенную активность (Фонштейн с соавт., 1985):
Если число колоний-ревертантов в опыте и
контроле достоверно различается менее чем в 2.5 раза, то делается заключение об
отсутствии мутагенной активности. Если фиксируют превышение от 2.5 до 10 раз,
то делается заключение о наличии мутагенной активности. Превышение от 10 до 100
раз говорит о средней мутагенной активности исследуемого соединения. Если
фиксируют превышение более чем в 100 раз, - вещество обладает сильной
мутагенной активностью.
2.1.5 Бактериальные тест - системы для
определения антимутагенных эффектов соединений природного происхождения
Для изучения антимутагенных свойств соединений
растительного происхождения использовали модификации теста Эймса: Тестерные
бактерии предварительно инкубировали с разными концентрациями биокомплексов и
мутагеном азидом натрия в течение 20 минут инкубировали с принудительной
аэрацией при 37оС для оценки биоантимутагенного эффекта, а затем в
верхний агар добавляли биотин с гистидином. Антимутагенный эффект исследуемого
соединения оценивали, сравнивая число колоний прототрофов, индуцированных
мутагеном без обработки клеток раствором исследуемых соединений, и после
преинкубации клеток с раствором и мутагеном. Антимутагенный эффект рассчитывали
по формуле:
Антимутагенный эффект (%)  ;
;
Где a -число His+
ревертантов в положительном контроле,
b - числоHis+
ревертантов в опытном варианте,
c- числоHis+
ревертантов в негативном контроле.
Согласно Negi с соавторами [Negi etal., 2003],
ингибирование мутагенного эффекта менее чем на 25 % свидетельствует о слабой,
от 25 % до 40 % о средней, выше 40 % - о сильном антимутагеном эффекте.
.1.6 Статистическая обработка результатов
Статистическую обработку результатов проводили с
использованием стандартных математических методов в программе Microsoft Excel.
Группу данных считали однородной, если среднеквадратическое отклонение s
в группе не превышало 15%. Различие между группами считали достоверным при Р ≤
0.05.
2.2 Результаты исследований и их обсуждение
.2.1 Определение токсического действия
экстрактов лекарственных растений Chelidonium
majus L.,
Cichorium
intybus L.,
Tussilago
farfara L.
на выживаемость штамма Salmonella typhimurium
TA 100
Результаты анализа токсичности исследуемых
препаратов на штамме S. typhimurium ТА100 представлены на таблице 1.
Таблица 1 Влияние алкалоидов, водного экстракта
чистотела (ВЭЧ, ВЭЧ-1, ВЭЧ-2), на выживаемость штамма S.typhimurium
TA 100
|
Варианты
|
Количество
колоний /чашку
|
Выживаемость,
%
|
|
Контроль
ДМСО
|
31±2,5
|
100
|
|
Алкалоиды
|
13,5±0,4
|
43,5
|
|
Ал-1
|
16,5±0,9
|
53
|
|
Ал-2
|
26,5±2,1
|
86,4
|
|
Контроль
(дист.Вода)
|
198±9,3
|
100
|
|
ВЭЧ
|
150±8,0
|
75
|
|
ВЭЧ-1
|
156±8,2
|
78
|
|
ВЭЧ-2
|
160±8,3
|
80
|
Как видно из таблицы 1, водный экстракт чистотела
большого не оказывал существенного токсического действия на штамм Salmonella
typhimurium
TA 100 процент
выживаемости тестерного штамма составил 80% - 75%, тогда как раствор алкалоидов
Chelidonium
majus L.
снижал процент выживаемости тестерных бактерий до 43,5%.
Раствор алкалоидов Chelidonium
majus L. проявил дозо-зависимый бактерицидный эффект (таблица 1), при этом
выживаемость тестерных бактерий сократилась до 43,5% в присутствии исходного
раствора
Известно, что алкалоиды сангвинарин и
хелеритрин, присутствующие в небольших концентрациях в траве чистотела,
проявляют гепатотоксичность. Внутри брюшинное введение сангвинарина или
хелеритрина в дозе 10 мг/кг массы тела вызывало повреждение клеток печени и
повышало активность аланинаминотрансферазы и аспартатаминотрансферазы на 50 и
100% соответственно. Однако внутрибрюшинное введение сангвинарина или
хелеритрина в дозе 0.2 мг/кг массы тела в течение 55 дней не выявляло признаков
гепатотоксичности.
Исследование влияния экстрактов травы чистотела,
а также индивидуальных алкалоидов коптизина, хелидонина, протопина, хелеритрина
и сангвинарина на первичные гепатоциты обнаружило прямую корреляцию между
содержанием алкалоидов в экстракте и гепатотоксичностью. Это означает, что
гепатотоксической концентрацией для экстракта было 5 мг/мл; сангвинарина 5
мкг/мл; хелеритрина 8 мкг/мл [Монографии ВОЗ о лекарственных растениях, 2010].
Таким образом, данные литературы об
антибактериальной активности комплекса биологически активных веществ (БАВ)
данного растения полностью подтвердились [Samuelsen, 2000; Оленников с соавт.,
2007].
Результаты анализа токсичности исследуемых
экстрактов T. farfara L.
и C. Intybus
L. на штамме S.
typhimurium ТА100 представлены на таблице 2.
Таблица 2 Влияние водного экстракта
мать-и-мачехи обыкновенной (ВЭМ, ВЭМ-1, ВЭМ-2), водного экстракта цикория
обыкновенного (ВЭЦ, ВЭЦ-1, ВЭЦ-2) на выживаемость штамма S.typhimuriumTA
100
|
Вариант
|
Количество
колоний /чашку
|
Выживаемость,
%
|
|
Контроль
(дист.вода)
|
120±7,0
|
100%
|
|
ВЭМ
|
185±9,0
|
154%
|
|
ВЭМ-1
|
125±7,2
|
104%
|
|
ВЭМ-2
|
67,5%
|
|
ВЭЦ
|
195±9,3
|
162%
|
|
ВЭЦ-1
|
151±8,0
|
126%
|
|
ВЭЦ-2
|
167±8,5
|
139%
|
Как видно из таблицы 2, водный экстракт
мать-и-мачехи (T. farfara)
оказывал стимулирующее действие на рост штамма Salmonella
typhimurium
TA100, разница с
контролем составила 54%.
Целебные свойства мать-и-мачехи определяются её
химическим составом, который немного отличается в листьях и цветках. В листьях
имеются слизистые и дубильные вещества, горькие гликозиды, витамины (особенно
много аскорбиновой кислоты), микроэлементы, органические кислоты, инулин,
декстрин, ситостерин, каротиноиды, эфирные масла и т. д. В цветках к тому же
имеются тритерпеновые спирты и сигмастерин.
Так как в мать-и-мачехе содержаться
пирролизидиновые алкалоиды, а их токсичность изучена слабо, поэтому рекомендовано
не применять ее (особенно цветки) более 4-6 недель подряд [Vorobijeva, 2012].
Как видно из таблицы 2, водный экстракт цикория
обыкновенного (C. intybus
L.), не только не
проявил токсических эффектов на штамм Salmonella
typhimurium
TA 100 в исследованном
спектре концентраций, но и стимулировал рост бактерий, разница с контролем
составила 26% - 62%.
Цикорий корневой обладает целебными свойствами,
так как кроме инулина (до 61 %) и фруктозы (до 3 % к массе СВ) содержит целый
комплекс ценных веществ: левулезу (10 - 20 %),белковые вещества - 3,6; жир -
0,3; безазотистые экстрактивные вещества - 15,4; горький гликозид интибин;
пектин, холин, дубильные вещества. Установлено, что в корнеплодах цикория
содержатся 33 элемента (в больших количествах - никель, цирконий, ванадий,
железо, хром, цинк, медь) и витамины А, Е, В1, В2, В12, РР, С [Яценко с соавт,
1997].
Инулин эффективен при лечении атеросклероза,
сахарного диабета, ожирения, различных интоксикаций, его производные обладают
противоопухолевым действием [Пащенко, 2007]. Имеются данные об образовании
комплексов инулина с Ca, Ba, Sr, что свидетельствует о его способности выводить
ионы тяжелых металлов, яды, радионуклиды, причем в 2,5 раза интенсивнее, чем
пектин. Биологически активные вещества цикория рефлекторно усиливают секрецию
желудочного и кишечного сока, повышают аппетит. Корни цикория не проявляют
выраженного побочного действия и не являются токсичными. Однако при
продолжительном применении они могут значительно усиливать выделение
желудочного сока и желчи [Пащенко, 2007].
Таким образом, проведенное исследование
позволяет сделать вывод о дифференциальном токсическом действии препаратов
растения Ch. majus L., T.
farfara L.
и C. intybus
L. Так, нами
показано, что алкалоид Chelidonium majus L. обладал антибактериальной
активностью в отношении бактерий S. typhimurium. В то же время водный экстракт
чистотела не оказывал существенного угнетающего действия на рост тестрных
бактерий.
Водные экстракты T.
farfara L.
и C. intybus
L. по отношению к
штамму S.typhimuriumTA
100 проявили ростостимулирующее действие, что свидетельствует о возможности
тестирования экстрактов на антимутагенную активность в тесте Эймса.
По всей видимости, такое неодинаковое действие
препаратов Chelidonium majus L., Cichorium
intybus L.,
Tussilago
farfara L.
на микроорганизмы объясняется разницей химического состава комплекса БАВ.
.2.2 Мутагенные эффекты экстрактов лекарственных
растений Chelidonium
majus L.,
Cichorium
intybus L.,
Tussilago
farfara L
Результаты мутагенной активности исследуемых
соединений на штамме S. typhimurium ТА100 представлены на таблице 3.
Как видно из таблицы 3 водный экстракт чистотела
большого во всех разведениях не индуцировали заметного превышения над
спонтанным фоном мутирования штамма TA100
Salmonella
typhimurium. Раствор
алкалоидов Chelidonium majus L. также не проявил мутагенной активности в тесте
Эймса.
При исследовании водных экстрактов Tussilago
farfara L.,
Cichorium
intybus L.
В тесте Эймса было показано, что число индуцируемых мать-и-мачехой обыкновенной
и цикорием обыкновенным в концентрациях l:10, 1:100 мкг/мл His+ревертантов,
не превышало спонтанный фон мутирования (таблица 3). Так как число
колоний-ревертантов в опыте и контроле различаются менее чем в 2.5 раза, то
можно считать, что исследованные экстракты мать-и-мачехи и цикория не обладают
мутагенной активностью в тесте Эймса.
Таблица 3 Результаты оценки мутагенного эффекта
водного экстракта (ВЭЧ, ВЭЧ-1, ВЭЧ-2) и раствора алкалоидов чистотела большого,
водного экстракта мать-и-мачехи обыкновенной, водного экстракта цикория
обыкновенного на штамме S.typhimurium
TA 100 в тесте Эймса
|
Вариант
|
Число
колоний His+
ревертантов/чашку
|
|
НК
|
85±2,6
|
|
ПК
|
287±6,4
|
|
ВЭЧ
|
60,5±1,8
|
|
ВЭЧ-1
|
76±2,3
|
|
ВЭЧ-2
|
70±2,1
|
|
ВЭМ
|
106±6,5
|
|
ВЭМ-1
|
51±3,9
|
|
ВЭМ-2
|
71±5,0
|
|
ВЭЦ
|
68±4,8
|
|
ВЭЦ-1
|
97±6,1
|
|
ВЭЦ-2
|
76±5,2
|
|
НК
ДМСО
|
81±5,3
|
|
АЛ-1
|
83±5,5
|
|
АЛ-2
|
95±6,0
|
|
АЛ-3
|
104±6,4
|

А
Б
Рисунок 1. Различные количества колоний -
ревертантов в позитивном контроле (А) и в негативном контроле (Б)


2 3
 4
4
Рисунок 2. Мутагенный эффект водного экстракта
(1.ВЭЧ-1, 2.ВЭЧ-1:10, 3.ВЭЧ-1:100) чистотела большого на штамме S.
typhimurium
TA 100 в тесте Эймса,
позитивный контроль (4)


2 3
Рисунок 3. Мутагенный эффект водного экстракта
(1.ВЭЦ-1, 2. ВЭЦ-2) Cichorium
intybus L.
на штамме S. typhimurium
TA 100 в тесте Эймса,
позитивный контроль (3)
Таким образом, на основании результатов,
полученных в бактериальной тест-системе (тест Эймса), исследованные экстракты
лекарственных растений Chelidonium
majus L.,
Cichorium
intybus L.,
Tussilago
farfara L.
можно охарактеризовать как нетоксичные и немутагенные в исследованном диапазоне
концентраций.
.2.3 Антимутагенные эффекты экстрактов
лекарственных растений Chelidonium
majus L.,
Cichorium
intybus L.,
Tussilago
farfara L
При исследовании водных экстрактов и алкалоидов
лекарственных растений на штамме S.
typhimurium
TA 100, максимальный
антимутагенный эффект в отношении известного мутагена азида натрия, был
установлен для водного экстракта T.
farfara L.
как неразбавленного, так и в разведении ВЭМ 10-1 75,2 %, 58 %,
соответственно. При последующем разведении водного экстракта мать-и-мачехи ВЭМ
10-2 антимутагенный эффект составил всего16,4 %(рисунок 6).
Известно, что листья мать-и-мачехи содержат горькие
гликозиды, сапонины, каротиноиды, галловую, яблочную и винную кислоты,
ситостерин, аскорбиновую кислоту, слизи, дубильные вещества, следы эфирного
масла, минеральные соли, полисахариды инулин идекстрин (Кирпичников, 1981;
Мать-и-мачеха обыкновенная - Tussilago farfara L., 2010).
Более того, в ряде исследований показано, что
бутират, образующийся при бактериальной ферментации инулина, обладает
противоопухолевым действием [Reddyetal., 1997; Валышев, 2000].
Для алкалоидов Ch.
majus L.
в разведениях Ал 10-1, Ал 10-2 эффективность
антимутагенного действия достигла 64,3% и 42,4%. При последующем разведении
алкалоидов Ch. majus
L. Ал 10-3 составило
36 %, что свидетельствует о среднем ингибировании мутагенного эффекта (рисунок
7).
Максимальный антимутагенный эффект был
установлен для водного экстракта Ch.
majus L.
неразбавленного (ВЭЧ) составило 44,8 %.
При последующем разведении водного экстракта Ch.
majus L.
ВЭЧ 10-1 ВЭЧ 10-2 составило
29 %, 18,4, что свидетельствует о среднем и слабом ингибировании мутагенного
эффекта (рисунок 8).
Имеется ряд исследований, свидетельствующих об
антиканцерогенном действии экстрактов растений чистотела большого. Ким и Ли
[Kim, Lee, 1997] показали, что экстракт растений чистотела оказывает
ингибирующее действие на развитие опухоли желудка.
Даже очень низкие дозы гомеопатического
препарата Chelidonium 30 и Chelidonium 200 оказывали терапевтический эффект при
индуцированном гепатоканцерогенезе у мышей [Карамова, 2010].
Установлено, что экстракт из Ch. majus L.
обладает сильным антиоксидантным действием и ингибирует пролиферацию опухолевых
клеток [Nadova, 2008]. Бисвас с соавт. [Biswasetal., 2008] показали, что
экстракт чистотела большого обладает антикластогенным эффектом, снижая частоту
хромосомных аберраций и микроядер в клетках костного мозга мышей. Известно, что
чистотел большой содержит значительное количество биологически активных
веществ: дубильные вещества, флавоноиды, сапонины, витамины А и С, органические
кислоты (1,4-4,32 %),представленные хелидоновой, лимонной, яблочной,
аскорбиновой и янтарной.
Данное растение характеризуется наличием
алкалоидов (около 28 видов), оказывающих селективное цитостатическое действие
на опухолевые клетки человека в условиях in vitro.
Экстракт корней, листьев растения содержит
бензофенантридиновые алкалоиды, такие как хелидонин, хелеритрин, берберин идр.,
с которыми связывают антиканцерогенные эффекты экстрактов данного растения
[Карамова, 2010].
Из результатов, представленных на рисунке 9,
видно, что предварительная инкубация клеток тестерных штаммов с водным экстрактом
Cichorium
intybus L.
как неразбавленного, так и в разведениях ВЭЦ 10-1, ВЭЦ 10-2 ингибирование
мутагенного эффекта составил 63,3 %, 59,4 % и 45,5 %, что свидетельствует о
сильном антимутагеном эффекте.
Актуальным на сегодняшний день является использование
диетических пищевых волокон в продуктах питания, поскольку они обладают широким
спектром действия на организм человека.
Инулин и олигофруктоза - растворимые диетические
волокна являются избирательными стимуляторами роста и энергетическими субстратами
для бифидобактерий, что, в свою очередь, подавляет рост ряда вредных штаммов
микроорганизмов.
Инулин влияет на биологическую усвояемость
кальция и магния, на снижение уровня холестерина и липидов в сыворотке крови.
Инулин и олигофруктоза не повышают уровень глюкозы в крови, поскольку их
гликемический индекс практически равен нулю.
Наилучшим источником инулина и олигофруктозы
является цикорий корнеплодный [Резникова, 2009].

Рисунок 6. Антимутагенное действие водного
экстракта мать-и-мачехи обыкновенной в тесте Эймса. ВЭМ, ВЭМ 10-1,
ВЭМ 10-2 - водный экстракт мать-и-мачехи обыкновенной в
соответствующих разведениях. НК - негативный контроль, ПК - Азид натрия
(позитивный контроль), 4 мкг/чаш. % - Антимутагенный эффект

Рисунок 7. Антимутагенное действие алкалоидов
чистотела большого в тесте Эймса. Ал 10-1, Ал 10-2, Ал 10-3
- алкалоиды чистотела в соответствующих разведениях. НК - негативный контроль,
ПК - Азид натрия (позитивный контроль), 4 мкг/чаш. % - Антимутагенный эффект

Рисунок 8. Антимутагенное действие водного
экстракта чистотела большого в тесте Эймса. ВЭЧ, ВЭЧ 10-1, ВЭЧ 10-2
- водный экстракт чистотела в соответствующих разведениях. НК - негативный
контроль, ПК - Азид натрия (позитивный контроль), 60 мкг/мл. % - Антимутагенный
эффект

Рисунок 9. Антимутагенное действие водного
экстракта цикория обыкновенного в тесте Эймса. ВЭЦ, ВЭЦ 10-1, ВЭЦ 10-2
- водный экстракт цикория обыкновенного в соответствующих разведениях. НК -
негативный контроль 4 мкг/чаш., ПК - Азид натрия (позитивный контроль), 60
мкг/мл. % - Антимутагенный эффект
Таблица 4 Результаты оценки антимутагенного
эффекта водного экстракта (ВЭЧ, ВЭЧ-1, ВЭЧ-2) и раствора алкалоидов (Ал-1,
Ал-2, Ал-3) Chelidonium
majus L.,
водного экстракта (ВЭМ, ВЭМ-1, ВЭМ-2) Tussilago
farfara L.,
водного экстракта (ВЭЦ, ВЭЦ-1, ВЭЦ-2) Cichorium
intybus L.на
штамме S. typhimurium
TA 100 в тесте Эймса
|
Вариант
|
Число
колоний His+
ревертантов/чашку
|
Антимутагенный
эффект, %
|
|
ПК
|
368±13,1
|
|
|
ВЭЧ
|
232±10,2
|
44,8
|
|
ВЭЧ-1
|
280±11,3
|
29
|
|
ВЭЧ-2
|
312±12,0
|
18,4
|
|
ВЭМ
|
140±7,7
|
75,2
|
|
ВЭМ-1
|
192±9,2
|
58
|
|
ВЭМ-2
|
318±12,1
|
16,4
|
|
ВЭЦ
|
176±8,7
|
63,3
|
|
ВЭЦ-1
|
188±9,1
|
59,4
|
|
ВЭЦ-2
|
230±10,2
|
45,5
|
|
НК
|
65±4,7
|
|
|
Ал-1
|
168±8,5
|
64,3
|
|
АЛ-2
|
236±10,3
|
42,4
|
|
Ал-3
|
256±10,8
|
36
|
|
НК
ДМСО
|
57±4,3
|
|
Итак, нами показано, что водный экстракт
мать-и-мачехи обыкновенной неразбавленный проявил максимальный антимутагенный
эффект, при последующем разведении антимутагенный эффект снижался. Водные
экстракты цикория обыкновенного как неразбавленный, так и в разведениях
проявили сильный антимутагенный эффект. Водные экстракты чистотела большого
проявили средний антимутагенный эффект, в то же время раствор алкалоидов
показывал сильный антимутагенный эффект.
. Выявлено, что водные экстракты
чистотела большого не оказывали существенного токсического действия на
тестерный штамм Salmonella
typhimurium
TA 100, тогда как
раствор алкалоидов Chelidonium
majus L.
снижал процент выживаемости данных бактерий 2,5 раза. Водные экстракты Tussilago
farfara L.
и Cichorium
intybus L.
проявили ростостимулирующее действие на штамм S.
typhimurium
TA 100.
. Водные экстракты лекарственных растений
и выделенные алкалоиды охарактеризованы как немутагенные в исследованном
диапазоне концентраций.
. Антимутагенный эффект неразбавленных
водных экстрактов возрастал в ряду: чистотел большой (45%)→цикорий
обыкновенный (63%)→мать-и-мачеха обыкновенная (75%). При разбавлении
растворов (1:10, 1:100) выявленная закономерность сохранялась. Антимутагенность
выделенных алкалоидов чистотела была выше, чем у водных экстрактов этого
растения, а эффект разбавления - ниже.
СПИСОК ИСПОЛЬЗОВАННЫХ ИСТОЧНИКОВ
1. Абдрахимова
Й.Р. Вторичные метаболиты растений: физиологические и биохимические аспекты.
Часть 2. Алкалоиды: Учебно-методическое пособие. - Казань: Каз. гос. ун-т.,
2009. - 40 с.
. Алекперов,
У.К. Антимутагенез. Теоретические и прикладные аспекты [Текст]/ У.К. Алекперов.
- М.: Наука, 2009.- С. 100.
. Андреева
И.И., Родман Л.С. Ботаника. - 3-е, перераб. и доп.. - М: Колос, 2005. - С. 399.
- 528.
. Барабанов
Е.И. Ботаника: учебник для студ. высш. учеб.заведений. - М: Издательский центр
«Академия», 2006. - С. 230-241.
. Баширова
Р.М., Усманов И.Ю., Ломаченко Н.В.//Вещества специализированного обмена
растений (Классификация. Функции): учебное пособие /Под ред. Г.П.Яковлева. -
СПб.: Спец Лит, 2006. 845 с.
. Блинова
К.Ф. // Ботанико-фармакогностический словарь: справочное пособие. - М.: Высшая
школа, 1990. - С.272.
. Булатов
А.А., Бузук Г.Н., Ловкова М.Я., Сабирова Н.С.// Изменчивость качественного и
количественного состава алкалоидов чистотела большого в течение вегетации. //
Хим-фарм.ж., 2006, №5, С. 50 - 53.
. Бутенко
Р.Г. Клеточные технологии для получения экономически важных веществ
растительного происхождения//Культура клеток растений и биотехнология/ Под ред.
Р.Г.Бутенко. - М.: Наука, 1986.-243с.
. Веселовская
Н. В., А. Е. Коваленко.// Наркотики. - М.: Триада-X, 2000. - С. 6-14.
. Волощук
Т.П., Потопольский А.И. Об алкалоидном составе семян чистотела
большого//Фундаментальные исследования.-2010.-Научный журнал ISSN 1812-7339.-
С. 79-84.
. Гаммерман
А.Ф. Курс фармакогнозии. - Л.: Медицина, 1967. -703 с.
. Государственная
фармакопея СССР. Вып. 2. Общие методы анализа. Лекарственное растительное
сырье. -11-е изд. - М.: Медицина, 1990. 400 с.
. Гринкевич
Н. И., Сафронич Л. Н. Химический анализ лекарственных растений: Учеб.пособие
для фармацевтических вузов. - М.: 1983. - С. 126-132.
. Ефимов
С.Н. Изучение антимутагенной активности природных биологически активных веществ
околоплодника гречихи посевной / С.Н. Ефимов, А.Г. Семенов, Д.Л. Стахеев //
Современные проблемы
фундаментальной
и клинической медицины: Сборник статей молодых ученых и студентов / результаты
60-ой юбилейной конференции им. Н.И. Пирогова. - Томск, 2001. - С.131-132.
. Ильинская
О.Н. Маргулис А.Б. Краткосрочные тест-системы для определения генотоксичности
// (методическое руководство). - К.: Изд. КГУ, 2005. - 30 с.
. Карамова
Н.С., Фатыхова Д.Г., Абдрахимова Й.Р//Исследование антигенотоксических свойств
соков растений Chelidonium majus L., Plantago
major L., Тussilago farfara
L.- Экологическая генетика.- Казань.-2010.-Т8.- С. 56-59.
. Колычева
З.И. Биологическая химия. - Тобольск: ТГПИ им. Д.И.Менделеева, 2003. - С.
174-175.
. Мвапе
И., Абдрахимова Й. Р., Карамова Н.С//Сок растений чистотела большого снижает
генотоксический эффект фурацилина. Казань. 2010. С. 253-257.
. Муравьева
Д.А. Фармакогнозия (с основами биохимии лекарственных растений); под ред. Д. А.
Муравьева.- М.: Медицина, 1978. - С. 625-627.
. Монографии
ВОЗ о лекарственных растениях, широко используемых в Новых независимых
государствах (ННГ)// ISBN 978924 459772 9/2010. 451 с.
. Орехов
А.П. Химия алкалоидов. - М.:АН СССР, 1955.-868с.
. Палов
М., Энциклопедия лекарственных растений// в кн.: Действующие вещества
растительного происхождения; Издательство «Мир» - Москва,1998. - С 350.
. Племенков
В. В. Введение в химию природных соединений. - Казань: 2001. - с. 253.
. Пащенко
Л.П. с соавт., Перспективы применения цикория в производстве диабетических
хлебобулочных изделий// Фундаментальные исследования.-2007.-Научный журнал ISSN
1812-7339.- С. 25.
. Попов
А.М. Противоопухолевая активность вторичных метаболитов морских
беспозвоночных/Вестник ДВО РАН. 2006. №5. С. 81-90.
. Семёнов
А. А., Карцев В. Г. Основы химии природных соединений. - М.: ICSPF, 2009. - Т.
2.
. Потопальский
А.И. Препараты чистотела в биологии и медицине. Киев. Наукова думка. 1992.,
237с.
. Фонштейн
Л.М. Методы первичного выявления генетической активности загрязнителей среды с
помощью бактериальных тест-систем// Методическое указание.- М.- 1985. - 34 с.
. Яценко
А.А., Корниенко А.В., Жужжалова Т.П. Цикорий корнеплодный. - Воронеж: ВНИИСС,
2002. - 135 с.
30. Aniszewski,
T. Alkaloids - secrets of life. - Amsterdam: 2007. - p. 110-111.
. Gershenzon
J. Plant Defenses: Surface Protectants and Secondary Metabolites.
InPlantPhysiology, 3nd ed., L. Taiz, 2003. PP. 347-376.
. Mitsuoka
T, Hidaka H, Eida T., 1987. Effect of fructo-oligosaccharides on intestinal
microflora. Nahrung 1987;31:427-436 19
33. Hesse.
M. Alkaloids. Nature’s Curse or Blessing. - Wiley-VCH, 2002. - p. 204.
. Kada,
T. Mutation and environmental studies: Scientific reports of the research
project[Text]/T. Kada//Environment cleaning by microorganisms. -2006. - P.
695-648.
. Vorobijeva,
L.I.Abilev S.K. Antimutagenic properties of bacteria: review [Text] /
L.I.Vorobijeva,S.K. Abilev//Applied Biochemistry and Microbiology. - 2002.
V.38. - N2. -P. 97-107.
. Spiller
G. A., Caffeine. - USA: CRC Press, 1997. - Introduction to the chemistry,
isolation, and biosynthesis of methylxanthines.
. Kada,
T. Desmutagens and bioantimutagens- their modes of action [Text]/ T.
Kada//Bioassays.-2006.-V.7.-P. 113-116.
38. Kada,
T. Environmental antimutegens and carcinogens [Text]/ T. Kada, Eds T. Sigimura,
S. Kondo, H. Takebe.- 2006.- P. 355.